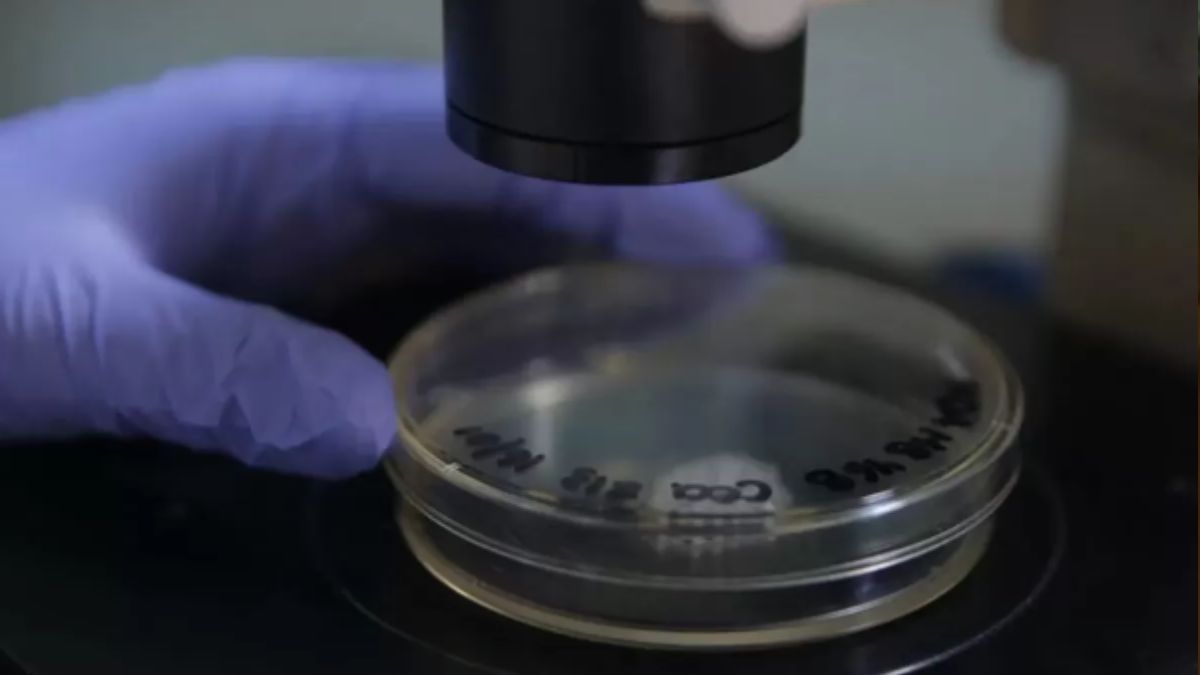
Se aprobó en el país una nueva terapia que permite tratar 17 tipos de tumores sólidos&nbsp;

Cómo actúa la nueva droga contra 17 tipos de cáncer que se aprobó en Argentina
Se aprobó en el país una nueva terapia que permite tratar 17 tipos de tumores sólidos
Dos días después de que se conmemorara el Día Mundial Contra el Cáncer se aprobó en el país una nueva terapia que permite tratar 17 tipos de tumores sólidos que incluyen, entre otros, de mama, colon y recto, pulmón, páncreas, cabeza y cuello, cerebro, melanoma y sarcoma.
Te podría interesar
Se calcula que hay más de 130 mil nuevos casos de cáncer por año en Argentina, siendo los más frecuentes los de mama, colon y pulmón y la mayoría de los tumores poco frecuentes están ubicados en órganos diferentes.
Generan síntomas variados en los pacientes, quienes ven afectada su vida de manera distinta. Sin embargo, a muchos los une que es la misma alteración genética del tumor la que favorece su desarrollo y crecimiento.
La investigación en oncología es una de las áreas que más avanza y acaba de aprobarse en nuestro país entrectinib, una nueva terapia "agnóstica de tumor", es decir, que no está indicada para uno o más tipos determinados de cáncer, como es habitual.
La Administración Nacional de Medicamentos, Alimentos y Tecnología Médica (ANMAT) la autorizó para cualquier tipo de tumor sólido que presente alteraciones genéticas específicas (que técnicamente se denominan ‘fusiones’) en los genes NTRK1, 2 y 3. Las alteraciones genéticas como éstas se determinan mediante estudios moleculares que se realizan en el país.
Más allá de los resultados esperanzadores que demostró esta nueva medicación, lo innovador y más original es que no está aprobada para uno, dos o cinco tipos de cáncer.
Se indica para inhibir las alteraciones de los genes NTRK que favorecen el crecimiento de algunos tumores, independientemente de si estos se alojan en el cerebro, en la mama, en el colon o donde sea.
Entonces, todo paciente que se realice un testeo molecular y presente alguna fusión de los genes NTRK podría beneficiarse con esta terapia", sostuvo el Dr. Claudio Martín (M.N. N° 82.958), médico oncólogo, Jefe de Oncología Torácica del Instituto Alexander Fleming.
La fusión de alguno de los tres genes NTRK está presente en hasta el 90% de los tumores poco frecuentes. Puede darse en sarcomas, glioblastoma, cáncer de páncreas, pulmón, mama, melanoma, cabeza y cuello, incluyendo tiroides, y colorrectal, entre otros.
El especialista explicó: "Si bien en el mundo estamos yendo al oncólogo por subespecialidades según el órgano afectado, los nuevos tratamientos ‘agnósticos’ dan vuelta ese paradigma porque hacen que se evalúen o dirijan las terapias por la alteración molecular del tumor, la que puede aparecer en distintos órganos, glándulas y tejidos".
La llegada de estas innovadoras opciones de tratamiento agnóstico representa un cambio fundamental en la forma en que se piensa el cáncer: desde el diagnóstico, el diseño de estudios clínicos y la priorización de medicamentos.
"Si bien el porcentaje de positividad de la fusión de los genes NTRK en algunos de los tumores más frecuentes es baja, las terapias agnósticas de tumor tienen un potencial absolutamente transformador. La ciencia está avanzando para contribuir a dar respuesta en el abordaje de casos complejos de cáncer. Es una nueva mirada de la oncología, producto de una mayor comprensión sobre cómo los tumores se desarrollan y crecen", afirmó el Dr. Martín.
Un segundo mecanismo sobre el que entrectinib también es eficaz, es en el que se altera otro gen, el ROS1, presente entre 1 o 2% de los casos de cáncer de pulmón de células no pequeñas metastásicos, y la ANMAT también aprobó el uso de entrectinib en esos casos.
Tal como refirió el oncólogo: "El cáncer de pulmón es uno de los más frecuentes en nuestro país, aunque ya entendimos que requiere un abordaje muy diferente según cuál sea el gen que está alterado. En todos los casos, continúa siendo un desafío por la existencia de necesidades insatisfechas. En ese contexto, nuevos mecanismos de acción como el de esta medicación ayudan a brindar más y mejores respuestas".
Dentro de lo que se conoce como medicina personalizada o de precisión, identificar la alteración genética que el tumor presenta permite determinar el tratamiento más conveniente.
"Tras decodificar el genoma de cada tumor, sabemos que, si indicamos la medicación dirigida para inhibir ese mecanismo tumoral, obtendremos mejores resultados que utilizando las medicaciones tradicionales, con mucha menos toxicidad que la quimioterapia, por ejemplo, y evitando dilapidar recursos en tratamientos que serán menos efectivos o que le harán perder al paciente tiempo valioso e irrecuperable", especificó el Dr. Martín.
"El testeo molecular hoy debería ser un estudio de rutina inmediatamente después del diagnóstico, porque es la llave para indicar el tratamiento más indicado. Es algo que puede realizarse en el país y es más accesible que antes, pero no todos los pacientes están en las mismas condiciones de acceder en tiempo y forma", reconoció.
Qué demostró esta nueva medicación
Tres estudios clínicos evaluaron la eficacia y seguridad de la nueva medicación, en pacientes con distintos tipos de cáncer y fusiones en los genes NTRK y ROS1. De los 150 pacientes con múltiples tipos de cáncer con fusiones de NTRK tratados con entrectinib, en el 61% disminuyó el tamaño de su tumor y en 25 casos se obtuvo respuesta completa, es decir, eliminación total del tumor. Entre los que redujeron sus tumores, la mediana de duración de la respuesta fue de 20 meses, incluso en personas con metástasis en el sistema nervioso central. La sobrevida libre de progresión fue de 13.8 meses y la sobrevida global, de 37.12.
"Son resultados más que alentadores y eran impensados poco tiempo atrás, sobre todo porque estamos hablando de tumores difíciles de tratar y enfermedades complejas en estadios avanzados", sostuvo el Dr. Martín.
Además, el 67,9% de los 168 pacientes con cáncer de pulmón de células no pequeñas con fusiones ROS1 disminuyó el tamaño de su tumor, incluyendo 22 pacientes que obtuvieron respuesta completa.
La mediana de la respuesta fue de 20.5 meses. En tanto, la mediana libre progresión fue de 15.7 meses y la sobrevida global, de 47.8 meses.
Asimismo, demostró reducir en más de la mitad tumores que habían hecho metástasis en el sistema nervioso central, al igual que otro estudio, que arrojó respuestas sorprendentes, rápidas y duraderas, con disminuciones significativas en el tamaño de los tumores en el sistema nervioso central en todos los pacientes.
"Estos resultados sobre metástasis cerebrales que presentan este cambio molecular específico, abren una esperanza para muchos pacientes, por lo que esperamos que en los próximos años sigan desarrollándose nuevas terapias, que -solas o en combinación- nos ayuden a seguir avanzando en el camino para lograr cronificar el cáncer", concluyó el médico.








